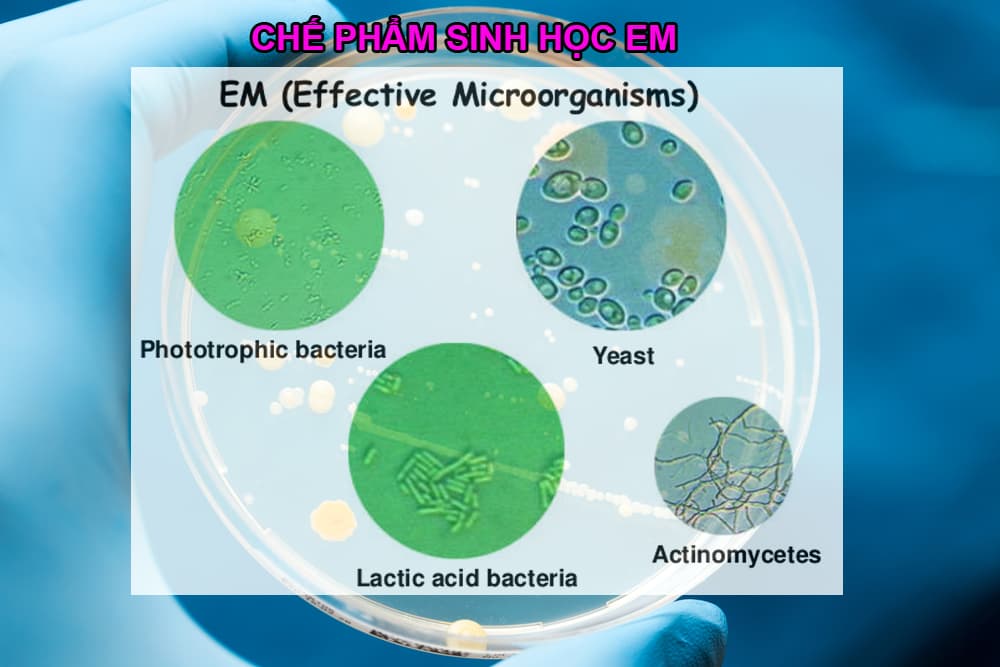
Chế phẩm sinh học EM

chế phẩm sinh học EM là một trong những phát minh nổi bật của ngành công nghệ sinh học nói chung và ngành công nghệ lên men nói riêng ở cuối thế kỷ 20. Với nhiều tác dụng ưu việt và đa chức năng, chế phẩm EM nhanh chóng được nghiên cứu mở rộng và ứng dụng trên toàn thế giới. Vậy chế phẩm sinh học EM là gì? Lợi ích, công dụng và cách pha chế chi tiết nhất? Mời các bạn hãy cùng Chế phẩm vi sinh Đức Bình tìm hiểu chi tiết qua bài viết dưới đây nhé!

Trong thời đại ngày nay, xu hướng sử dụng các sản phẩm sinh học đang ngày càng tăng. Các chất hóa học tuy có hiệu quả trong kinh tế nhưng lại gây ảnh hưởng lớn tới môi trường. Đặc biệt trong nông nghiệp, nhu cầu này lại cao hơn bao giờ hết. Chế phẩm sinh học EM là một sản phẩm ra đời từ nhu cầu đó.
1. Tìm hiểu về chế phẩm sinh học Em
1.1 Chế phẩm sinh học EM là gì?
EM là viết tắt của Effective Microorganisms trong tiếng Anh, được hiểu là các vi sinh vật hữu hiệu. Chế phẩm này được Giáo sư Tiến sĩ thiên tài người Nhật Bản Teruo Higa sáng chế ra. Nó được thử nghiệm và sau đó áp dụng thực tế từ năm 1980.
Thành phần chính của chế phẩm EM – chế phẩm sinh học EM gốc bao gồm hơn 80 loài sinh vật kị khí và hiếu khí. Các nhóm phổ biến: vi khuẩn quang hợp, lactic,..nấm men, nấm mốc và xạ khuẩn. Quá trình chọn lọc các loài này diễn ra rất phức tạp và tốn nhiều công sức. Do đó phải lựa chọn, theo dõi tác động, hoạt hóa của tới 2000 loài mới chọn ra được.
Nguyên lý của nó dựa trên việc hoạt động của vi sinh vật. Từ đó tạo ra ác chất chống oxy hoá như inositol, ubiquinone, saponin, polysaccharide phân tử thấp, polyphenol và các muối chelate. Nó còn tạo ra các enzym phân giải cũng như cộng hưởng sóng trọng lực.
Ngày nay, chế phẩm này được sử dụng rộng rãi trong các công nghệ thực phẩm, lên men cũng như các lĩnh vực sinh học thực tiễn khác.
Tóm lại, EM (Vi sinh vật hữu hiệu) là tập hợp các loài vi sinh vật có ích (vi khuẩn quang hợp, vi khuẩn lactic, nấm men, xạ khuẩn, nấm mốc), sống cộng sinh trong cùng môi trường. Có thể áp dụng chúng như là một chất cấy nhằm tăng cường tính đa dạng vi sinh vật đất, bổ sung các vi sinh vật có ích vào môi trường tự nhiên, giảm thiểu sự ô nhiễm môi trường do các vi sinh vật có hại gây ra.
1.2 Thành phần chính của chế phẩm EM
Chế phẩm sinh học EM là loại sản phẩm sinh học đa dụng, có nhiều chức năng khác nhau. Ở mỗi điều kiện phù hợp ( hiếu khí hay hiếm khí) sẽ kích thích chức năng hoạt động của các chủng vi sinh phù hợp.

Trong chế phẩm EM có nhiều chủng vi sinh vật ( cả hiếu khí lấn hiếm khí) và đươc chia làm 5 nhóm chính sau:
- Nhóm vi khuẩn quang hợp: có chức năng tổng hợp chất hữu cơ từ năng lượng ánh sáng tạo ra nguồn dinh dưỡng thiết yếu cho các loại vi sinh vật trong chế phẩm sinh học. Chính vì vậy các vi sinh vật trong chế phẩm EM, sống cộng sinh với nhau, hỗ trợ nhau sinh trưởng và phát triển.
- Nhóm vi sinh vật Lactic: Sản xuất ra axit lactic, giúp ức chế các loại vi sinh vật gây hại, tạo môi trường ưa thích cho các loại vi sinh vật khác trong hệ sinh thái phát triển và phân giải các chất hữu cơ.
- Nhóm Nấm men: Sản sinh ra các loại vitamin, acid amin, hormone tăng trưởng, enzyme … thúc đẩy quá trình phân giải các chất hữu cơ, cải thiện môi trường sống cho hệ vi sinh vật hữu ích. Những sản phẩm được tạo ra trong quá trình trao đổi chất của nấm men lại là dinh dưỡng cho các nhóm vi sinh khác trong chế phẩm.
- Nhóm xạ khuẩn: Là vi sinh vật là trung gian giữa vi khuẩn và nấm chính là nhóm xạ khuẩn. Nhóm xạ khuẩn tham gia hoạt động rất mạnh trong quá trình phân giải các hợp chất hữu cơ: xenlluloz, tinh bột, lignin, protein … Ngoài ra các xạ khuẩn còn sinh ra các chất kháng sinh, có tác dụng diệt nấm bệnh và vi khuẩn gây hại.
- Nhóm Nấm sợi: sản sinh ra men ( enzyme) thuỷ phân tinh bột, xenlluloz, lignin, protein, lipit … dễ dàng và nhanh chóng tạo ra các dưỡng chất có lợi cho môi trường, Nấm sợi tham gia vào quá trình phân giải các hợp chất hữu cơ, khử mùi hôi thối của rác thải, nước thải … rất hiệu quả
Như vậy, mỗi loại vi sinh vật có trong chế phẩm vi sinh EM có chức năng hoạt dộng riêng rẽ. Chúng sống cộng sinh, tương hỗ nhau trong cùng một môi trường. Chính vì vậy, hiệu quả hoạt động tổng hợp của chế phẩm được tăng lên rất lớn..
2. Các loại chế phẩm EM chuyển hoá từ Em gốc
Em gốc có 2 loại, đó là Em gốc dạng bột và Em gốc dạng dịch. Để sử dụng hiệu quả và tiết kiệm chi phí, Chế phẩm sinh học Em thường được điều chế từ Em gốc (EM1) chuyển hoá thành nhiều dạng khác nhau để phù hợp với từng mục đích sử dụng.
2.1 Chế phẩm EM gốc (EM 1)
Chế phẩm EM gốc hay còn gọi là EM1. Chế phẩm vi sinh EM gốc có 2 loại: EM gốc dạng dịch ( Em gốc cho nông nghiệp Emgro, Em gốc cho thuỷ sản) và EM gốc dạng bột ( Men vi sinh EMZEO, Emzeo TS). EM gốc được sử dụng để sản xuất, sinh khối ra các dòng chế phẩm EM thứ cấp như: EM2, EM5, EM Bokashi, EM chuối, EM tỏi, EM trầu …

Dung dịch EM gốc là chất lỏng có màu nâu vàn với mùi dễ chịu, nếm có vị chua ngọt. Độ pH <3,5. Bảo quản EM1 ở nhiệt độ bình thường, ổn định, tránh ánh sáng trực tiếp của mặt trời. Thời gian bảo quản trong 12 – 18 tháng. Nếu thấy trên bề mặt có lớp váng mỏng màu trắng khi bảo quản, lớp vi sinh vật này không có hại và không ảnh hưởng đến chất lượng sản phẩm. Cách nhận biết EM gốc dạng dịch và dạng bột là chế phẩm vi sinh vật hữu hiệu và mật độ vi sinh vật > 10^8 CFU/ml hoặc CFU/gr ( một gram hoặc 1 ml chế phẩm chứa hàng tỉ vi sinh vật).

2.2 Chế phẩm EM2
Là loại chế phẩm thứ cấp, được tạo ra bằng cách sinh khối dịch EM1 với mật rỉ đường và nước sạch. 1 lít chế phẩm EM gốc sản xuất ra được 50 lít EM2 Thời hạn sử dụng chế phẩm EM2 ngắn, khoảng từ 3 – 6 tháng
2.3 Chế phẩm EM5
EM5 còn có tên gọi khác là EM rượu, được tạo ra bằng cách ủ EM gốc + rượu + dấm + rỉ đường + nước sạch Chế phẩm EM5 có tác dụng phòng chống sâu bệnh hại cây trồng bằng cách xua đuổi côn trùng, EM5 không gây độc hại cho con người, môi trường và vật nuôi
2.4 EM Bokashi
EM bokashi là loại chế phẩm EM thứ cấp dạng bột, được sản xuất bằng cách lên men cám gạo hoặc mùn cưa với mật rỉ đường và men vi sinh EM gốc. Có 2 loại EM Bakashi:
- Bokashi B: được sử dụng làm thức ăn cho vật nuôi.
- Bokashi C: được sử dụng để xử lý môi trường
2.5 Chế phẩm EM thảo dược
EM thảo dược là dòng chế phẩm EM thứ cấp, được sản xuất bằng cách lên men các nguyên liệu thảo dược: tỏi, ớt, gừng, giềng, nha đạm … với chế phẩm EM gốc ( EMGRO) và mật rỉ đường ( có thể cho thêm rượu và giấm). Các loại EM thảo dược phổ biến như: EM tỏi, gừng, giềng, ớt … được sử dụng để nâng cao sức đề kháng, chống chịu bệnh cho cây trồng và vật nuôi
2.6 Chế phẩm EM thảo mộc
Chế phẩm EM thảo mộc là loại chế phẩm sinh học được lên men từ rau, củ, quả … với chế phẩm EM1, có tác dụng tạo ra loại GE hữu hiệu cho cây trồng. Chế phẩm EM thảo mộc tiêu biểu nhất là chế phẩm EM chuối ( dịch chuối, GE chuối), tưới cho hoa hồng, hoa lan, cây cảnh, rau củ …. rất hiệu quả. EM thảo mộc được sử dụng để bổ sung vào thức ăn cho vật nuôi hoặc pha loãng tưới cho cây trồng
3. Lợi ích của chế phẩm Em
3.1 Phân giải nhanh các chất thải hữu cơ, rác thải, phân chuồng
Các vi sinh vật trong chế phẩm sinh học EM tiết ra các enzyme sống: protease, lipase, Amylase, Cellulase … phân giải các chất cao năng khó tiêu trong rác thải hữu cơ, thành các chất có cấu trúc phân tử nhỏ hơn. Hệ vi sinh vật trong men vi sinh EM, sử dụng các chất được phân giải ra làm dinh dưỡng cho bản thân hoặc chuyển hóa thành các chất có lợi cho môi trường, cây trồng, vật nuôi … Chính vì cơ chế tác dụng mạnh mẽ này, mà EM sử dụng ủ phân chuồng ( lợn, bò, gà, dê, trâu, vịt …), bánh dầu, đậu tương, bã đậu nành, ủ cá … làm phân bón cho cây trồng.

3.2 Giảm mùi hôi thối của rác thải
Các vi sinh vật có trong EM sinh ra các chất kháng sinh, enzyem … giúp ức chế và tiêu diệt các vi sinh vật gây mùi, gây bệnh và cạnh tranh dinh dưỡng, không gian sống, lấy số lượng chèn ép, tiêu diệt các vi sinh vật gây hại, gây thối. Một số vi sinh vật trong men vi sinh EM có khả năng sử dụng các khí thối trong rác thải ( mercaptan, H2S, NH3, hợp chất nitơ …) làm thức ăn để sinh tổng hợp các chất dinh dưỡng khác hữu ích, do vậy EM loại trừ mùi hôi thối một cách nhanh chóng.
3.3 Cung câp hệ sinh thái vi sinh vật hữu hiệu cho môi trường
Men vi sinh EM có tác dụng thúc đẩy nhanh quá trình phân giải chất thải hữu cơ, tạo lập và phát triển mạnh hệ sinh thái vi sinh vật hữu hiệu trong môi trường, đất, nước … Sử dụng chế phẩm EM định kỳ thường xuyên là cách cung cấp và bổ sung cho môi trường hệ sinh thái vi sinh vật hữu hiệu … giúp môi trường, rác thải … luôn được xử lý hiệu quả.
3.4 Cải tạo đất trồng, tăng năng suất cây trồng
Chế phẩm EM có tác dụng đặc biệt đối với cây trồng do chức năng của nhóm vi sinh vật quang hợp, kích thích khả năng quang hợp của cây trồng sinh tổng hợp các chất hữu cơ, giúp cây trồng mau lớn, khỏe mạnh. EM còn nâng cao sức đề kháng, giúp cây trồng chống chịu với sâu bệnh và thích nghi với điều kiện ngoại cảnh tốt hơn. Sử dụng chế phẩm EMGRO pha với nước sạch tưới trực tiếp cho cây trồng hoặc ủ hạt giống … giúp kích thích nảy mầm mạnh, ra hoa và đậu quả nhiều.
Chế phẩm sinh học Em cung cấp cho đất hệ vi sinh vật hữu hiệu, kích hoạt mạnh mẽ hệ vi sinh vật có lợi. Chúng nhanh chóng phân giải chất hữu cơ và tái tạo lại cấu trúc đất. Nhờ vậy, đất trở nên tơi xốp, màu mỡ hơn hẳn, đồng thời tăng cường vượt trội khả năng giữ nước và hấp thụ dinh dưỡng. Kết quả là đất được bảo vệ khỏi xói mòn và bạc màu.

3.5 EM có tác dụng hữu ích với vật nuôi và thủy sản
Chế phẩm EM mang đến giải pháp sinh học toàn diện để cải thiện sức khỏe vật nuôi và xử lý môi trường hiệu quả:
-
Chăn nuôi: Khử mùi hôi chuồng trại chăn nuôi, làm đệm lót sinh học, giúp vật nuôi tiêu hóa tốt và giảm bệnh đường ruột. Đặc biệt, Chế phẩm EM nâng cao chất lượng thịt, trứng, sữa.
-
Thủy sản: Xử lý môi trường ao nuôi, khử khí độc, phân hủy nền đáy, và điều hòa tảo … tạo môi trường ao nuôi cân bằng, sạch sẽ.

4. Ứng dụng của chế phẩm sinh học EM
Do chứa nhiều chủng vi sinh vật khác nhau nên chế phẩm này đem lại nhiều tính năng đa dạng. Chế phẩm Em được ứng dụng rộng rãi trong trồng trọt, chăn nuôi, nuôi trồng thuỷ sản và xử lý môi trường.
4.1 Trong trồng trọt
- Cải tạo đất bạc màu: Tưới Em giúp đất tơi xốp, giàu dinh dưỡng, thoát nước tốt.
- Ủ phân hữu cơ từ rác thải, phân chuồng, phế phẩm nông nghiệp: Chế phẩm Em giúp đẩy nhanh phân huỷ sinh học, mùn hoá rơm rạ, cá cây, phân chuồng, cây xanh, rác thải hữu cơ … thành phân bón cây hiệu quả
- Tưới gốc và phun lá: Dung dịch Em pha loãng tưới cho cây trồng rất tốt. Em tưới gốc giúp bộ rễ cây phát triển mạnh mẽ, hấp thu dinh dưỡng hiệu quả. Em phun lá giúp cây tăng cường quang hợp, ngừa nấm bệnh hại cây hiệu quả.
- Xử lý ươm hạt giống và kích thích cây non phát triển: Ngâm hạt giống với Em pha loãng giúp tăng tỉ lệ nảy mầm, tưới Em cho cây con làm tăng khả năng chống chịu sâu bẹnh, cây khoẻ mạnh, lớn nhanh.

4.2 Trong chăn nuôi
- Xử lý mùi hôi chuồng trại chăn nuôi: Phun chế phẩm EM vào chuồng trại chăn nuôi giúp xử lý mùi hôi phân, nước tiểu nhanh chóng , ức chế và tiêu diệt mầm bệnh cho vật nuôi.
- Ủ thức ăn chăn nuôi: Chế phẩm Em ủ chua phế phẩm nông nghiệp (rơm rạ, cám ngô, cám gạo, cây chuối, rau xanh, cỏ …) làm thức ăn cho vật nuôi.
- Bổ sung vào thức ăn hoặc nước uống: Pha loãng Em cho vật nuôi uống hoặc trộn với thức ăn giúp vật nuôi tiêu hoá tốt, lớn nhanh, ít bệnh tật. Có thể làm chế phẩm Em tỏi gừng cho vật nuôi uống giúp nâng cao sức đề kháng, giảm thiểu mùi hôi phân thải ra.
- Ủ phân chuồng: Em giúp hoai mục phân thải vật nuôi nhanh chóng, khử mùi hôi thối … chế biến thành phân hữu cơ bón cho cây trồng.

4.3 Trong xử lý môi trường
- Chôn lấp rác thải đô thị: Quy trình xử lý như sau: Rác thu gom được đổ lên bãi, san lấp đạt chiều cao mỗi lướp rác khoảng 20cm, hòa tan EM2 với nước sạch theo tỷ lệ: 1/50, 1/100, 1/200, 1/300 tùy thuộc vào độ ẩm của rác, thông thường pha theo tỷ lệ 1/100, phun lên bãi rác. Làm như vậy đối với từng lớp rác của mỗi đợt thu gom. Không sử dụng vôi bột và thuốc diệt côn trùng ở trên bãi chôn lấp, chỉ sử dụng ở nơi xung quanh bãi
- Xử lý nước thải: bổ sung EM ngay từ giai đoạn đầu của hệ thống xử lý nước thải, nhằm thúc đẩy quá trình và tăng cường hiệu quả xử lý của hệ thống, EM có thể tăng cường khả năng xử lý của hệ thống cả dạng kỵ khí và hiếu khí. Để xử lý nước thải tù đọng ở ao, hồ, kênh mương…. Cần phải xử lý cả bùn đáy bằng EM Bokashi và xử lý nước thải bằng EM thứ cấp.
- Xử lý đất ô nhiễm: Em giúp phục hồi đất bị thoái hoá, ô nhiễm do hoá chất, do mất cân bằng sinh thái.
4.4 Trong nuôi trồng thủy sản
Hầu hết tất cả các vật nuôi thủy sản ( tôm, cá, ốc, ếch, lươn)… đều đã được ứng dụng thành công chế phẩm EM để xử lý môi trường ao nuôi.

Chế phẩm sinh học EM có rất nhiều tác dụng trong nuôi trồng thủy sản như:
- Tạo màu nước, điều hòa sự phát triển của tảo
- Phân hủy mạnh chất thải hữu cơ nền đáy: thức ăn dư thừa,
- Xử lý khí độc trong ao nuôi, ức chế và tiêu diệt các vi sinh vật gây bệnh
5. Cách pha chế EM gốc thành các chế phẩm EM2, EM5, EM tỏi, EM chuối, EM Bokashi…
5.1 Pha chế Em gốc thành chế phẩm EM2
- Công thức: 1 lít EM1 ( EMGRO, Em gốc thuỷ sản ) + 47 lít nước sạch + 3 lít mật rỉ đường ———> Ủ 5 – 7 ngày thu được 50 lít chế phẩm EM2
- Dùng EM gốc dạng bột: 1 gói Emzeo 200gr + 10 lít nước sạch + 1 lít mật rỉ đường
- Cách làm: Cho mật rỉ đường, nước sạch và thùng ủ và khuấy đều, sau đó cho EM gốc vào và khuấy nhẹ. Đậy nắp thùng ủ và để ở nơi thoáng mát, tránh ánh nắng trực tiếp, ủ trong thời gian 5 – 7 ngày. Thi thoảng mở nắp thùng ủ để thoát khí. EM2 đạt yêu cầu khi có mùi thơm nhẹ của dấm, pH khoảng 4.
5.2 Pha chế EM Bokashi
Bokashi B: được sử dụng làm thức ăn cho vật nuôi
Công thức: 1 lít EM gốc ( hoặc 2 gói Em gốc dạng bột) + 2 lít Rỉ đường + 40 lít Nước + (70 – 100kg) thức ăn ủ kín 5-7 ngày ==> Bokashi B
Thành phần nguyên liệu ủ thức ăn: bột ngô, bột cám, bột cá,..) được phối trộn theo tỷ lệ nhất định đảm bảo tỷ lệ đạm và dinh dưỡng cần thiết cho vật nuôi.
Cách ủ
- Trộn đều các thành phần thức ăn, sau đó vừa phun dung dịch trên vào hỗn hợp vừa trộn cho đến khi độ ẩm đạt 30 – 40% là được.
- Cho vào bao hoặc thùng chứa, bao kín để lên men kỵ khí.
- Sau 5-7 ngày, Khi hỗn hợp có mùi lên men ngọt, thơm, có mốc trắng trên bề mặt, có nghĩa EM bokashi B đã làm xong và đem dùng.
Bokashi C: EM Bokashi xử lý môi trường
Công thức ủ: 5 lít EM gốc + 5 lít Rỉ đường + 50 lít Nước + 100kg Cám gạo, mùn cưa ủ kín 7-10 ngày =====> Bokashi C
Cách ủ
- Cám gạo và mùn cưa được chia theo tỷ lệ 1:1. Trộn đều các thành phần, sau đó vừa phun dung dịch lên các hỗn hợp vừa trộn cho đến khi độ ẩm đạt 30 – 40 % là được.
- Cho vào bao hoặc thùng chứa, bao kín để lên men kỵ khí.
- Sau 7 – 10 ngày, khi hỗn hợp có mùi lên men ngọt, thơm, có mốc trắng trên bề mặt.
Cách sử dụng
– Sử dung Bokashi C để làm đệm lót sinh học: Trộn đều với trấu hoặc mùn cưa để lót chuồng trại chăn nuôi
– Ủ phân chuồng, rác hữu cơ: Dùng 15kg Bokashi C đảo đều 1 tấn rác thải, thêm nước đạt độ ẩm ủ, đậy bạt kín ủ phân
– Ngoài ra EM Bokashi C còn được sử dụng để xử lý nước thải, môi trường …
5.3 EM gốc pha chế thành phân bón cho cây trồng
Sử dụng chế phẩm EM gốc ( EMGRO) pha loãng với nước sạch để tưới gốc hoặc làm phân vi sinh phun qua lá cho cây trồng
Cách tưới gốc: 1 lít EMGRO pha với 200 lít nước sạch, tưới ướt đều khu vực quanh gốc cây. Lượng tưới tùy thuộc vào loại cây trồng và độ tuổi của cây
Phun qua lá: Pha loãng 1 lít EMGRO với 300 lít nước sạch, phun ướt đều trên toàn bộ lá, thân và gốc cây trồng. Nên phun vào sáng sớm hoặc chiều mát.Định kỳ 2 – 3 tuần tưới 1 lần, đối với rau màu: 1 tuần tưới 1 lần. Nên tránh phun lúc cây đang ra hoa, đậu quả.
5.4 Pha chế Em thảo mộc
Công dụng EM thảo mộc
– Giúp cây trồng khỏe mạnh, nâng cao sức đề kháng
– Bổ sung dưỡng chất cho cây, tăng năng suất cây trồng
Công thức sản xuất EM thảo mộc
250ml EMGRO + 1 lít mật đường + 1kg củ, quả + 8 lít nước —--> Đảo đều, đậy kín ủ 3 – 5 ngày —-> Thu được 10 lít EM thảo mộc
Cách sử dụng:
– Pha 1 lít EM thảo mộc với 40 – 50 lít nước sạch, phun tưới ướt đều cho toàn bộ cây trồng ( thân, lá, gốc)
– Định kỳ 7 – 10 ngày phun 1 lần
– Nên pha loãng cùng với chế phẩm nấm khối kháng Trichoderma để tăng hiệu lực đối kháng nấm bệnh cho cây trồng
– Hạn sử dụng của EM thảo mộc: dưới 3 tháng
6. 3 loại chế phẩm Em gốc được sử dụng phổ biến hiện nay
6.1 EM gốc dạng bột
Chế phẩm vi sinh EMZEO là dòng EM gốc dạng bột, phân hủy và khử mùi hôi chất thải hữu cơ. Được ứng dụng hiệu quả trong ủ phân cá, đậu tương, bánh dầu, trùn quế, bã đậu nành, phân chuồng, phế thải nông nghiệp…
6.2 Chế phẩm Em gốc trong nông nghiệp (Emgro)
Chế phẩm sinh học EMGRO là loại chế phẩm EM gốc ứng dụng trong nông nghiệp hiệu quả: ủ phân chuồng, khử mùi hôi chuồng trại, xử lý nước thải, rác thải, ủ thức ăn cho vật nuôi …
6.3 Chế phẩm Em gốc, Em1 trong nuôi trồng thủy sản
Chế phẩm sinh học EM gốc ( EM1) là loại men vi sinh EM gốc dạng dịch, sử dụng trong xử lý nước thải, tạo màu nước, xử lý đáy ao, khử khí độc … cực kỳ hiệu quả
7. Lưu ý khi sử dụng chế phẩm em
- Không sử dụng EM cùng với kháng sinh và hóa chất diệt khuẩn. Sử dụng đúng liều lượng. Không nên theo quan niệm sử sụng càng nhiều càng tốt.
- Thời gian sủ dụng chế phẩm em tốt nhất vào khoảng 8 – 10h sáng, lúc nắng ấm và tăng cường hàm lượng oxy hòa tan cao.
- Trong quá trình nuôi, cần định kỳ xử lý vi sinh để duy trì mật độ vi khuẩn thích hợp nhằm kiểm soát sinh học môi trường nước và đáy ao, ổn định các yếu tố môi trường ao nuôi, ngăn ngừa các loài vi khuẩn gây bệnh, tảo độc và mầm bệnh tiềm tang trong ao.
- Thành phần của chế phẩm EM chứa nhiều vi khuẩn hiếu khí (Bacillus) và vi khuẩn hiếu khí nghiêm ngặt (VK Nitrat). Vì vậy, để đạt được hiệu quả tốt nhất cần phải đảm bảo lượng oxy hòa tan đầy đủ bằng cách tăng cường sục khí, quạt nước…
- Hiệu quả sử dụng EM phụ thược vào sự ổn định của pH. Để pH ổn định nên duy trì độ kiềm trong nước trong khoảng 80 – 150 mg/l. Đồng thời, độ mặn quá cao sẽ gây chết hoặc ức chế sinh trưởng của vi sinh, nên cần kiểm tra mật độ mặn để cân nhắc việc sử dụng EM trong việc phòng, trị bệnh.
- Nên có kế hoạch sử dụng vi sinh từ đầu đến cuối vụ để có thể đạt được hiệu quả cao nhất. Đầu vụ, định kỳ sử dụng 7 – 10 ngày/ lần, từ giữa đến cuối vụ, sử dụng định kỳ 3 – 4 ngày/ lần.
Chú ý: Khi tảo chết nhiều, pH thấp, cần dung vôi để nâng pH

8. Hướng dẫn cách bảo quản
Việc bảo quản chế phẩm Em đúng cách giúp duy trì hiệu quả và kéo dài thời gian sử dụng sản phẩm
- Nơi bảo quản: Để sản phẩm nơi khô mát, tránh ánh sáng trực tiếp, nhiệt độ ổn định ( nhiệt độ phòng). Đảm bảo sản phẩm được vặn chặt kín khí sau mỗi lần lấy ra sử dụng.
- Sử dụng nước sạch không chứa Chlo: Nếu dùng nước máy nên để qua đêm, có thể dùng nước mưa, nước giếng khoan đã lọc kỹ.
- Thời hạn sử dụng: Em gốc dạng dịch có thời hạn sử dụng 18 tháng nếu còn nguyên vẹn. Em gốc dạng bột có hạn sd 24 tháng. Nên sử dụng hết trong vòng 3 tháng sau khi mở nắp chai EM gốc. Em thức cấp ( Em2, Em tỏi, Em chuối …): Nên sử dụng trong vòng 30 ngày sau khi pha chế
- Nhận biết Em bị hỏng: dung dịch EM có mùi thối hoặc có pH> 4 được coi là hỏng và không sử dụng được. Em thứ cấp còn tốt có mùi thơm của mật đường và rượu.
⫸ Xem thêm: Địa chỉ bán chế phẩm EM gốc ở đâu uy tín, chất lượng nhất
Thông tin liên hệ
Chế phẩm vi sinh Đức Bình – Trung Tâm nghiên cứu và ứng dụng chế phẩm sinh học
Địa chỉ : 1B Ngõ 774 Kim Giang, Thanh Liệt, Hà Nội
SĐT: 0934.214.579
Hotline: 024.66.55.46.86
Tư vấn kỹ thuật: 0915.79.80.85
Mua hàng/Zalo: 0986.658.698
Email: chephamvisinhungdung@gmail.com
Website: https://webvisinh-mai.webmanhan.com
FB: https://www.facebook.com/chephamvisinhhanoi
Shopee: https://shopee.vn/chephamemzeo
[sp_easyaccordion id=”29929″]
Qua bài viết trên, Chế phẩm vi sinh Đức Bình hi vọng cung cấp cho các bạn thông tin đầy đủ nhất về Chế phẩm sinh học EM là gì? Lợi ích, công dụng và cách pha chế Em chuẩn nhất. Ngoài ra, chúng tôi còn phân phối rất nhiều các dòng sản phẩm sinh học khác như: Men xử lý bể phốt, men xử lý nước hồ cá cảnh, chế phẩm nấm trichoderma bacillus … Rất hân hạnh phục vụ bà con những dòng sản phẩm chất lượng nhất với giá thành hợp lý


Cho xin giá EM gốc Việt Nhật can 20 lít chính hãng?